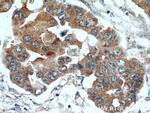
TPM2 Antibody in Immunohistochemistry (Paraffin) (IHC (P))

Search
Proteintech
TPM2 Polyclonal Antibody
{{$productOrderCtrl.translations['antibody.pdp.commerceCard.promotion.promotions']}}
{{$productOrderCtrl.translations['antibody.pdp.commerceCard.promotion.viewpromo']}}
{{$productOrderCtrl.translations['antibody.pdp.commerceCard.promotion.promocode']}}: {{promo.promoCode}} {{promo.promoTitle}} {{promo.promoDescription}}. {{$productOrderCtrl.translations['antibody.pdp.commerceCard.promotion.learnmore']}}
产品信息
11038-1-AP
种属反应
已发表种属
宿主/亚型
分类
类型
抗原
偶联物
形式
浓度
规格
纯化类型
保存液
内含物
保存条件
运输条件
产品详细信息
Immunogen sequence: MDAIKKKMQ MLKLDKENAI DRAEQAEADK KQAEDRCKQL EEEQQALQKK LKGTEDEVEK YSESVKEAQE KLEQAEKKAT DAEADVASLN RRIQLVEEEL DRAQERLATA LQKLEEAEKA ADESERGMKV IENRAMKDEE KMELQEMQLK EAKHIAEDSD RKYEEVARKL VILEGELERS EERAEVAESR ARQLEEELRT MDQALKSLMA SEEEYSTKED KYEEEIKLLE EKLKEAETRA EFAERSVAKL EKTIDDLEET LASAKEENVE IHQTLDQTLL ELNNL (1-284 aa encoded by BC011776)
靶标信息
TPM2 (tropomyosin 2) is beta-tropomyosin, an isoform of tropomyosin that is mainly expressed in slow, type 1 muscle fibers. TPM2 binds to actin filaments in muscle and non-muscle cells. Plays a central role in association with the troponin complex in the calcium dependent regulation of vertebrate striated muscle contraction. Smooth muscle contraction is regulated by interaction with caldesmon. Mutations in this gene can cause nemaline myopathy 4, arthrogryposis dital 1A/2B, and cap myopathy 2.
仅用于科研。不用于诊断过程。未经明确授权不得转售。
生物信息学
蛋白别名: Beta-tropomyosin; epididymis secretory protein Li 273; fibroblast tropomyosin; nemaline myopathy type 4; RP11-112J3.4; skeletal muscle beta-tropomyosin; tropomyosin; tropomyosin 2 (beta); Tropomyosin beta chain; Tropomyosin-2; unnamed protein product
基因别名: AMCD1; CMYO23; CMYP23; DA1; DA2B; DA2B4; HEL-S-273; NEM4; TMSB; Tpm-2; TPM2; Trop-2
UniProt ID: (Human) P07951, (Rat) P58775, (Mouse) P58774
Entrez Gene ID: (Human) 7169, (Rat) 500450, (Mouse) 22004